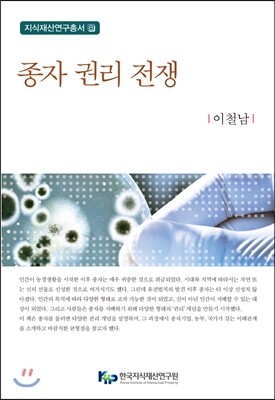
한국지식재산연구원.신론사  종자 권리 전쟁

한국지식재산연구원.신론사 종자 권리 전쟁

알림함